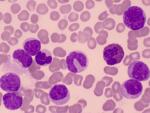
Chronic Myelogenous Leukemia (also called Myleoid Leukemia) many myeloblasts (immature white blood cells or leukocytes)

Leukemia is a type of cancer involving the blood and bone marrow, but it’s not uncommon for leukemia to affect the lymph nodes. This happens when leukemia cells travel from the bone marrow to the lymph nodes through the bloodstream. Depending on how many leukemia cells reach your lymph nodes, your leukemia may be classified as chronic lymphocytic leukemia (CLL) or small lymphocytic lymphoma (SLL). Understand the distinction and learn about traditional and new SLL treatment options.
Leukemia and Lymph Nodes: SLL Versus CLL
SLL is closely related to CLL, the most common type of leukemia in adults in the United States. They are both low-grade and slow-growing, or indolent. The main difference between the two has to do with the location of cancer cells in the body. With CLL, there are more cancer cells in the bone marrow and bloodstream. You may hear this referenced as a lymphocyte count over 500-meaning greater than 500 lymphocytes per 1.0 ml of blood. With SLL, there are more cancer cells in the lymph nodes. Because of this greater lymph node involvement, SLL is also considered a type of non-Hodgkin lymphoma.
Both SLL and CLL tend to affect older adults. It’s often diagnosed in people more than 60 years of age, and the average age at diagnosis is 65.
Traditional Treatments for SLL
Many people with SLL don’t experience symptoms at first. Often, people learn they have SLL when it’s found after a blood test for an unrelated reason. If you don’t have symptoms, you may not need treatment right away, and a “watch and wait” approach may be recommended to see if symptoms develop. Symptoms include anemia, enlarged lymph nodes, enlarged spleen, and a low platelet count that prevents blood from clotting (thrombocytopenia).
If you do have symptoms, chemotherapy to kill cancer cells will likely be the first treatment option considered. It can be given intravenously or by mouth in tablet form. Newer targeted therapies called monoclonal antibodies may be combined with chemotherapy or given alone. They work with the body’s immune system to target cancer cells and prevent their growth. They can be given intravenously, by mouth, or through an injection.
“Traditional” doesn’t mean these treatment options are old or out of date. They are continuously being refined through scientific research and clinical trials. Treatment plans for SLL are highly personalized, taking into account the severity of your symptoms, how fast the cancer is growing, your age, and your overall health.
New Treatments for SLL
When leukemia doesn’t respond as hoped to traditional treatment, you may hear it referred to as “refractory” or “relapsed.” This isn’t the end of treatment; it’s the beginning of new approaches. For examples, new treatments called biologics target cancer at the cellular level and are now approved to treat SLL. One biologic, venetoclax (Venclexta), has been shown to work when traditional chemotherapy doesn’t, especially in combination with a monoclonal antibody called rituximab (Rituxan). Patients can try the venetoclax/rituximab combination after undergoing at least one previous therapy. Another biologic, duvelisib (Copiktra), is an alternative for those who have already tried two other therapies. Both medications can be taken orally. Biologics have proven effective for many people and can be easier to tolerate than traditional chemotherapy. Depending on the specific biologic treatment, it may be given alone or combined with a traditional treatment.
Information about how different biologics work can be highly scientific and complex. Take the time to work through it and ask your doctor to help with the translation. Make sure you understand the thinking behind your current treatment, any previous treatments, and what might come next. If you have a thorough understanding of your treatment options, you’ll be better equipped to partner with your doctor, have confidence in your care, and gain greater peace of mind through the process.